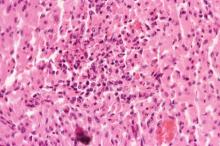
圖4：切片下心肌細胞呈岑克氏壞死，局部心肌細胞橫紋消失、肌細胞質顆粒化及肌細胞核濃縮及破裂等變化。

仔豬口蹄疫病毒人工感染病例
- 英文名稱
- Experimental Infection of Foot and Mouth Disease Virus in Piglets
- 作者
- 李淑慧 ;鍾明華; 張國慧; 黃天祥 ;林士鈺
- 建立日期
- 96年01月18日
- 更新日期
- 96年01月18日
- 內容
一、 病歷: 為瞭解口蹄疫病毒對仔豬引起心肌壞死之致病機轉,本試驗將10頭20日齡蘭嶼豬經
口接種 5 × 10 8 O/TWN/97 FMD病毒,每隔 6小時量體溫、採血、口腔咽喉及糞便拭子,
並進行抗體檢測、血清生化值分析及病毒分離。結果8/10頭仔豬接種病毒6小時後體溫明顯下降,活力減退,至36小時最低降至37.3
℃。所有接種仔豬除一頭仔豬耐過存活外,其餘仔豬皆陸續於感染病毒後24至70小時內
陸續死亡,其中以42小時死亡率最高(4/9)。二、 肉眼病變:
1. 試驗豬接種病毒後56小時突然發生呼吸困難。 2. 猝死仔豬有典型虎斑心病變 (圖1)。 3. 攻毒後42小時舌頭產生水泡病變 (圖2)。 4. 攻毒後72小時蹄冠產生水泡。 三、 組織病變: 1.
舌頭:
上皮細胞水腫變性,有些區域可見淺層之小潰瘍灶 (圖3)。 2.
心肌:
切片下心肌細胞呈岑克氏壞死,局部心肌細胞橫紋消失、肌細胞質顆粒化及肌
細胞核濃縮及破裂等變化 (圖4)。3.
蹄冠:
蹄冠上皮細胞水腫,大量細胞內水腫液聚積,匯集成水泡。 四、 實驗室檢驗: 1. 試驗豬接種病毒後12小時於血清可回收病毒,24小時後可於咽喉液及糞便拭子回收病
毒。2. 接種病毒12小時起10/10仔豬之LDH血清生化值明顯上升,3/10仔豬CK值開始上升。 五、 結果: 綜觀試驗仔豬之臨床症狀及病理學變化與86年臺灣爆發FMD時之野外病例一致。 六、 討論: 86年3月中旬,本省受口蹄疫病毒侵襲以來,最初顯現之臨床徵候為哺乳仔豬整窩暴
斃,最具特徵性變化為心肌急性帶狀壞死,肉眼病變呈黃白色桿狀樣壞死斑,又稱虎斑
心。依據文獻資料顯示 FMDV 可大量自乳汁排出,母豬感染 FMDV 後,哺乳豬吸吮含有FMDV 乳汁,大量病毒侵犯仔豬心肌,造成心肌的壞死。為進一步了解本病毒對初生仔
豬心肌之致病機轉,故本試驗以 FMDV 臺灣分離病毒株 (O/TWN/97),以經口感染方式餵
食病毒於初生仔豬,以確實瞭解 FMDV 於初生哺乳仔豬之致病機轉。由本次試驗結果發
現口服病毒的仔豬其臨床症狀及病理學變化與86年臺灣爆發 FMD 時之野外病例一致,於
猝死仔豬皆可見典型之「虎斑心」病變。而在保育豬及肥育豬方面,經李等於1999年人工感染保育豬及肥育豬試驗顯示,口
蹄疫病毒不會在保育豬及肥育豬心肌增殖,而僅在上皮細胞及一些唾液腺內增殖,保育
豬及肥育豬感染口蹄疫病毒後肉眼也不會發現「虎斑心」之病變,但顯微病變及血清生
化值卻顯現於心肌有顯著之傷害,此心肌之傷害似乎也與豬隻死亡有密切之關係。七、 參考文獻: 1.
Anderson EC. The pathogenesis of foot and mouth disease in the African buffalo (synceras
caffer) and the role of this species in the epidemiology of the disease in kenya. J Comp Pathol.
89:541-549,19792.
Brooksby JB. Strains of the virus of foot-and-mouth disease showing natural adaptation to
swine. J Hyg 47(2): 184-195, 1950.3.
Chang TC, Chang CC, Tasi SS, Chang GN, Kuo M, Chung WB. Short communication: An
outbreak of foot-and-mouth disease in pigs in southern Taiwan. J Chin Soc Vet Sci 23(3):
269-273, 1997.4.
Chu RM, Yang PC, Cheng IV. Foot-and-mouth disease:Review. J Chin Soc Vet Sci 23(6):
477-491, 1997.5.
Donaldson A I. Foot-and-mouth disease in Taiwan. Vet Rec 140(15): 407, 1997. 6.
Dunn CS, Donaldson AI. Natural adaption to pigs of a Taiwanese isolate of foot-and-mouth
disease virus. Vet Rec 141: 174-175,1997.7.
Donaldson AI, Ferris NP, and Wells GAH. Experimental foot-and-mouth disease in fattening
pigs, sow, and piglets in relation to outbreaks in the field. Vet Rec 115: 509-512,1984.8.
Shieh HK. The FMD situation in Taiwan: Short communication. J Chin Soc Vet Sci. 23(5): 395-
402, 1997.